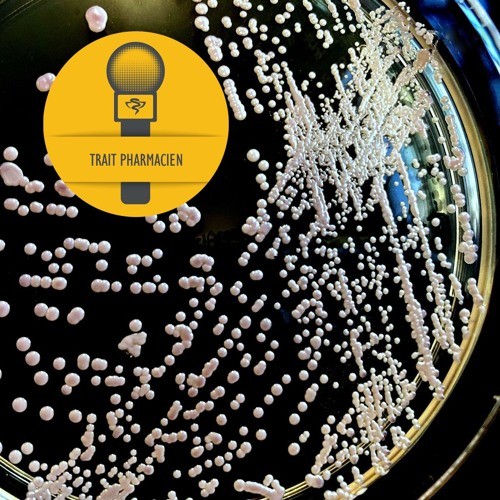

Épisode 82 | Antifongiques : pour qui et quoi surveiller?
3 juin 2024
Invité(e)s : Alexandre Rivard et François Bourdeau, pharmaciens au Centre universitaire de santé McGill
Durée: 00:31:50
Les infections microbiennes sont souvent synonymes d’infections bactériennes ou virales, comme la pneumonie ou l’influenza. Mais qu'en est-il des infections fongiques? En fait, elles ne sont pas à négliger : les infections fongiques graves, qui affectent surtout les patients plus vulnérables, sont associées à près de deux millions de décès chaque année. Pour cet épisode, Trait pharmacien reçoit Alexandre Rivard et François Bourdeau, pharmaciens au Centre universitaire de santé McGill, pour discuter des antifongiques et des particularités de leur suivi. François est également membre du Regroupement de pharmaciens experts en infectiologie de l’A.P.E.S. et récipiendaire du Prix d’excellence pour la relève 2024.
Références
- Lignes directrices du programme d’antibiogouvernance du Centre universitaire de santé McGill
- Pappas PG, Kauffman CA, Andes DR et coll. Clinical practice guideline for the management of candidiasis: 2016 update by the IDSA. Clin Infect Dis 2016;62(4):e1-50.
- Patterson TF, Thompson GR III, Denning DW et coll. Clinical practice guideline for the diagnosis and management of aspergillosis: 2016 update by the IDSA. Clin Infect Dis 2016;63(4):e1-60.
- Cornely OA, Alastruey-Izquierdo A, Arenz D et coll. Global guideline for the diagnosis and management of mucormycosis: An initiative of the ECMM in cooperation with the MSGERC. Lancet Infect Dis 2016;19(12):e405-21.
- Laverdiere M, Bow EJ, Rotstein C et coll. Therapeutic drug monitoring for triazoles: A needs assessment review and recommendations from a Canadian perspective. Can J Infect Dis Med Microbiol 2014;25(6):327-43.


